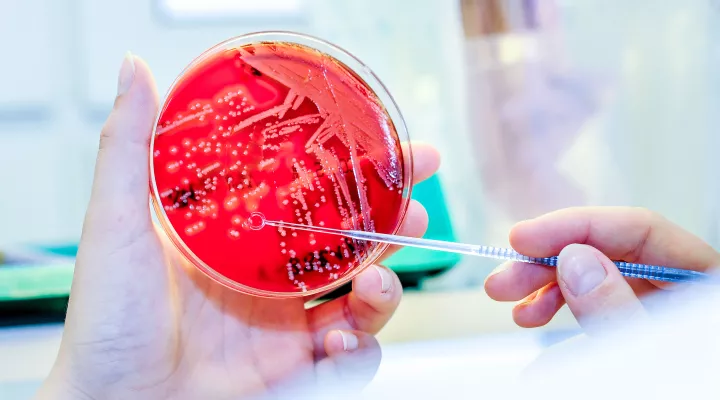
Infektiologie, Laborantin ruehrt mit einem Stab in der Petrischale

Infektiologie & Spitalhygiene
Wir behandeln abwehrgesunde und abwehrgeschwächte Neugeborene, Säuglinge, Kinder und Jugendliche mit Infektionen aller Art.
Wir legen höchsten Wert auf eine umsichtige Planung von Abklärung und Therapie, von Kindern mit Infektionskrankheiten, um den individuellen Bedürfnissen des Kindes und seiner Familie gerecht zu werden.
In enger interdisziplinärer Zusammenarbeit beteiligen wir uns an der Betreuung von Kindern und Jugendlichen, bieten einen Konsiliardienst rund um die Uhr und betreiben ein eigenes Diagnostik- und translationales Forschungslabor. Die Spitalhygiene steht ausgerichtet auf die Besonderheiten eines Kinderspitals zur Verfügung und verfolgt höchste Qualitätsstandards. Wir sind vernetzt mit den Kinderkliniken, Kinderärztinnen und Kinderärzten in der Region und beraten diese bei infektiologischen Fragen.
Für infektiologische Konsilanfragen (nur für externe Fachpersonen) nutzen Sie bitte unser Onlineformular.
Wir sind eine SIWF-anerkannte Weiterbildungsstätte für Infektiologie (A).
Infektiologie
Die Abklärung, Therapie und Betreuung erfolgt bei ambulanten Patientinnen und Patienten mit Infektionskrankheiten auf unserer spezialisierten Poliklinik oder Tagesklinik und konsiliarisch auf der Notfallstation. Stationäre Kinder betreuen wir interdisziplinär ab Eintritt via Notfallstation, während der gesamten Hospitalisationsdauer und bis hin zur Nachsorge auf der Poliklinik oder Tagesklinik. Unsere Diagnostik- und Forschungslaboratorien sind auf dem neuesten Stand der Technik. Die Therapien werden nach den aktuellsten internationalen Empfehlungen durchgeführt.
Spitalhygiene
Die Spitalhygiene trägt zur Verhütung, Erkennung und Bekämpfung von nosokomialen Infektionen sowie deren Ausbreitung bei. Der Fokus liegt auf den Besonderheiten eines Kinderspitals unter Berücksichtigung höchster Qualitätsstandards. Die Schwerpunkte unserer Tätigkeit sind Infektionsprävention und -überwachung, Qualitätsmanagement sowie Reinigung, Desinfektion, Sterilisation und Personalschutz. Unser Team aus Fachexpertinnen für Infektionsprävention und Infektiologinnen und Infektiologen berät zudem Institutionen und Stellen ausserhalb des Kinderspitals.
Mikrobiologie-Labor
Wir betreiben eigene Diagnostik- und Forschungslaboratorien auf neuestem Technologiestand. Das Mikrobiologie-Labor untersucht mit modernsten Methoden diverse Untersuchungsmaterialien gemäss höchsten internationalen Qualitätsstandards.
Unser Leistungsangebot
Schwere und invasive Infektionen
Schwere und invasive Infektionen sind infektiologische Notfälle. Die Erkennung dieser Krankheiten stellt eine Herausforderung für Kinderärztinnen und Kinderärzte dar. Die Abklärung und Therapie von Kindern mit invasiven Infektionen wie Sepsis und Meningitis erfolgt mit höchster Fachkompetenz.
Dabei arbeiten wir eng mit den spezialisierten Behandlungsteams und Zentren wie Intensivmedizin, Neonatologie, Onkologie, Chirurgie, Neurologie oder dem Zentrum für brandverletzte Kinder zusammen und leiten die korrekte Diagnostik und Therapie dieser Infektionen ein.
Chronische Infektionen (Tuberkulose, HIV und andere konnatale Infektionen)
Die Betreuung von Patientinnen und Patienten mit chronischen Infektionen erfolgt durch unser Team basierend auf internationalen Empfehlungen.
Die Erfahrungswerte und die Vernetzung eines universitären Zentrums sind essentiell für die optimale Behandlung von Kindern mit chronischen Infektionen wie HIV und Tuberkulose, welche glücklicherweise in der Schweiz selten geworden sind.
Infektionen bei immunkompromittierten Kindern
Die Verhütung, Diagnose und Therapie von Infektionen bei abwehrgeschwächten Patientinnen und Patienten stellt eine grosse Herausforderung dar.
In enger Zusammenarbeit mit Spezialistinnen und Spezialisten der Onkologie, Transplantationsmedizin und Immunologie stellen wir die kontinuierliche und optimale Betreuung von immunkompromittierten Kindern sicher.
Atemwegsinfektionen
Atemwegsinfektionen sind die häufigsten Infektionskrankheiten im Kindesalter sowie ein Schwerpunkt unserer klinischen und wissenschaftlichen Arbeit. Die Pneumonie (Lungenentzündung) ist eine der häufigsten Indikationen für die Verschreibung von Antibiotika.
Zusammen mit den behandelnden Ärztinnen und Ärzten kümmern wir uns um eine korrekte Diagnose und rationale Therapie. Zudem betreuen wir Patientinnen und Patienten mit Komplikationen einer Pneumonie (sog. Pleuropneumonie mit Ansammlung von Flüssigkeit im Pleuraspalt).
Antimikrobielle Therapie und Antimicrobial Stewardship
Unsere Therapien werden nach den aktuellsten internationalen Empfehlungen durchgeführt. Wir erstellen hausinterne Leitfäden als Basis für eine kalkulierte antimikrobielle Therapie.
Die oberste Priorität ist dabei eine umsichtige Planung der Therapie, um den individuellen Bedürfnissen des Kindes und seiner Familie gerecht zu werden. Zudem legen wir grossen Wert auf eine rationale, verantwortungsvolle Antibiotikatherapie, die auf einem Erregernachweis basiert. Wir setzen nur geeignete Antibiotika mit der richtigen Therapiedauer, Dosierung und Darreichungsform ein («Antimicrobial Stewardship»). Dadurch soll ein maximaler Therapieeffekt bei minimaler Resistenzentwicklung erreicht werden.
Fieber (prolongiert, rezidivierend, Fiebersyndrome)
Fieber ist ein Zeichen der aktiven Immunabwehr des Körpers. Es gibt verschiedene Ursachen dafür. Fieber ist keine Diagnose, sondern ein Symptom, das der weiteren Abklärung bedarf.
Meist liegt dem neu aufgetretenen Fieber eine infektiöse Ursache zugrunde. Selten gibt es auch nicht-infektiöse Ursachen, bei denen zunächst das Fieber im Vordergrund steht. Bei rezidivierendem Fieber ohne Hinweise auf Erreger müssen auch periodische Fiebererkrankungen in Erwägung gezogen werden. Wir kümmern uns um die Abklärung von allen Formen von Fieber und betreuen Patientinnen und Patienten mit rezidivierendem Fieber.
Impfungen, Reisemedizin und Migrationsmedizin
Wir legen grossen Wert darauf, dass nicht nur gesunde Kinder, sondern vor allem auch Kinder mit chronischen Krankheiten dank einer Impfung vor Erkrankungen geschützt werden.
In diesem Sinn beraten wir im ambulanten und stationären Bereich Kolleginnen und Kollegen in der Erstellung eines individuellen Impfplans für ihre Patientinnen und Patienten. In unserer Sprechstunde bieten wir zudem Impfberatungen für besondere Fragestellungen oder auf Wunsch von Eltern an. Ebenso beraten wir Familien vor Reisen bezüglich Impfungen und anderer Prophylaxe-Massnahmen. Für Kinder, die in die Schweiz gezogen oder adoptiert worden sind, bieten wir eine medizinische Standortbestimmung inklusive detaillierter Impfempfehlung an.
Zeckenübertragene Erkrankungen
Zeckenübertragene Krankheiten treten in der Schweiz saisonal gehäuft auf. Hier sind vor allem Borreliose und Frühsommer-Meningoenzephalitis (FSME) von Bedeutung.
Seltener sind Krankheiten wie die Tularämie. Borreliose und Tularämie: Sie können antibiotisch behandelt werden. Eine ursächliche Behandlung der FSME ist nicht möglich. Hingegen steht eine gut wirksame Impfung zur Verfügung. Die Abklärung von durch Zecken übertragenen Infektionskrankheiten ist ein wichtiger Bestandteil unserer konsiliarischen Tätigkeit. Zudem betreuen wir Kinder, welche aufgrund einer Borreliose eine ambulante intravenöse Antibiotikatherapie benötigen.
Unser Kontakt
Bitte beachten Sie, dass die Anmeldung ausschliesslich auf ärztliche Zuweisung erfolgt.
Wir sind telefonisch für Sie erreichbar:
Montag bis Freitag: 08.30 - 11.30 Uhr / 13.30 - 16.30 Uhr
Dispo Infektiologie und Spitalhygiene
- Anfragen zu Terminen (Vereinbarungen/ Verschiebungen)
- Anfragen zu Rezepten, Verordnungen
Office Infektiologie und Spitalhygiene
- Zuweisungen
- Berichts-/ Befundanfragen
- Versicherungsanfragen
Universitäts-Kinderspital Zürich – Eleonorenstiftung
Abteilung Infektiologie und Spitalhygiene
Lenggstrasse 30
8008 Zürich
Anfragen für externe Fachpersonen
Infektiologie
Externe Ärztinnen und Ärzte haben die Möglichkeit über das Konsilformular eine infektiologische Beratung durch das infektiologische Ärzteteam des Kinderspital Zürich anzufordern.
Das Onlineformular führt Sie gezielt durch die für uns relevanten Angaben. Wenn vollständig ausgefüllt, wird Ihre Anfrage mit «absenden» direkt unserem infektiologischen Ärzteteam übermittelt und in der Regel innerhalb von zwei Arbeitstagen bearbeitet.
Für klare ärztliche Zuweisungen bitten wir Sie das Formular für Zuweisende auszufüllen.
Wichtiger Hinweis:
Anfragen von Patientinnen, Patienten oder deren Eltern sowie allgemeine Auskünfte können nicht beantwortet werden.
Bei dringenden Fällen wenden Sie sich bitte telefonisch an die Assistenz Infektiologie +41 44 249 64 43 oder an die Rezeption des Kinderspitals +41 44 249 49 49.
Spitalhygiene
Auskünfte und Beratungen der Spitalhygiene des Kinderspitals Zürich für fachliche Unterstützung in Hygienefragen in der Pädiatrie sind bei freier Kapazität möglich. Anfragen vor Ort oder nach Vereinbarung.